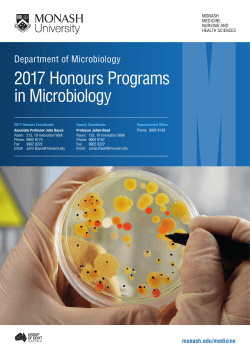
Microbiology Honours Degree - Medicine, Nursing and Health

-
technical documentation
-
Science and Nature
-
Religion
-
Health and Medicine
-
Travel
-
Automotive
-
Business and Leadership
-
Design
-
Economy and Finance
-
Education
-
Software and Internet
-
Entertainment and Humor
-
Cooking and Food
-
Government and Nonprofit
-
Lifestyle and Career
-
Real Estate
-
Sports and adventure
-
Crafts and Hobbies
© Copyright 2026 Paperzz